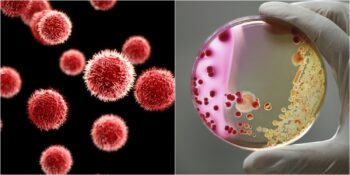
Covid-19 Pandemisinin Ardından Çığ Gibi Büyüyen İlginç Topluluk: Mikrop İnkârcıları

Her Bütçe ve Damak Tadına Uygun Çekirdek Kahve Önerileri
Kahve, dünya genelinde en çok tüketilen içeceklerden biridir ve bu lezzetli içeceğin en iyi versiyonlarından biri hiç kuşkusuz çekirdek kahvedir. Çekirdek kahve, kahve tutkunlarının damaklarını şımartan ve...